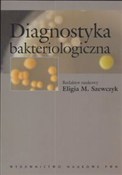
Polska książka : Diagnostyk...

Filtruj według ceny
Filtrowanie według atrybutów
- Dostępność
- ukryj niedostępne
- Wysyłka
- szybka wysyłka
- Przecena
- 15% lub więcej
- 30% lub więcej
- 50% lub więcej
Diagnostyka medyczna
|
€70,38
|
Wady serca Tom 1 [Twarda]
|
€29,64
|
Otologia kliniczna [Twarda]
Zapraszamy do zakupu produktów z tej kategorii.